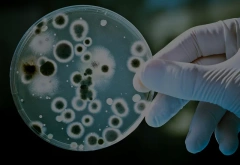
VITA单菌种单细菌转录组测序

VITA单菌种单细菌转录组产品为单菌的单细胞转录组测序提供解决方案。通过ⅥTApilote®高通量单菌种单细菌转录组试剂盒、VITAcruizer®单细胞制备仪及VITAseer®分析软件组成的完整平台,可实现对每个样本1,000-20,000个细菌进行转录组检测,进行mRNA研究。
产品优势

实测数据

应用方向
耐药性研究:
细菌耐药性存在巨大个体差异,将VITA产品应用于细菌耐药性研究,可进一步推动细菌耐药机制的深入挖掘。
时序研究:
细菌耐药性存在巨大个体差异,将VITA产品应用于细菌耐药性研究,当细菌在不同状态之间转变时,往往会经历转录重组,导致一些基因被重新激活,但纯化这些瞬态细胞进行研究难度较大。由于菌落内部异质性,bulk-RNAseq很可能会丢失关键信息。 VITA产品可以完美应用于微生物的时序表达分析。
细菌与细胞互作:
细菌耐药性存在巨大个体差异,将VITA产品应用于细菌耐病原菌与宿主细胞的相互作用对其致病性至关重要。宿主细胞在感染时可通过调整代谢途径来增强抵抗和清除病原菌的能力;而病原菌则可通过不同的机制操控宿主细胞代谢,促进自身生存。VITA产品可应用于细菌与细胞互作研究。